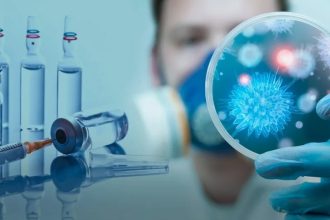

Сколиоз — это стойкое искривление позвоночного столба во фронтальной плоскости. При котором происходит поворот вокруг продольной оси. Изменения затрагивают и внутренние органы. Они сдавливаются, меняют свое положение, что в последующем приводит к нарушению их функциональности. Нарушение осанки у детей чаще формируется в период интенсивного роста.
Сколиоз диагностируется у 5-10% детей. В категорию риска попадают дети в возрасте от 5 до 12 лет. В этот период позвоночник интенсивно растет. Если ребенок неправильно сидит за партой, не занимается спортом, сколиоз развивается особенно быстро.
С каждым годом растет число детей с нарушениями осанки. Многие специалисты отмечают тенденцию к увеличению количества юных пациентов с разными формами заболевания. В большинстве случаев это связано с нарушениями осанки. Компьютеры, гаджеты, при использовании которых дети могут долго находиться в неудобной, сгорбленной позе, недостаток физической активности, огромный объем домашних заданий и дополнительных занятий, требующих сидения за партой – все это способствует неравномерному распределению нагрузки на позвоночный столб.
В школе дети часто сидят с опущенным плечом, с приподнятой половинкой таза, с подложенной под таз ногой, закидывают руки на спинку стула, поворачивают корпус, или же сидят на краю стула, далеко отставленного от стола, при этом подолгу оставаясь в согнутом положении.
Большую часть дня школьники проводят, склонившись над тетрадками и книжками, ведь учебный процесс продолжается и в школе, и дома. Сознательные родители проявляют бдительность и тщательно следят за тем, чтобы ребенок не делал уроки, сидя с искривленной спиной. Ведь такое положение, если оно уже стало систематическим и вошло в привычку, может привести к искривлению позвоночника. К слову, у 40 % учеников старших классов наблюдается деформация позвоночника, которая требует серьёзного лечения.
Родители в данном случае поступают правильно, следя за осанкой своего ребенка-школьника. Однако неправильная поза за столом – в большинстве случаев, уже следствие искривления позвоночника, а не его причина.
Если у ребёнка появились незначительные отклонения от нормальной осанки, то их можно вначале устранить благодаря простым упражнениям. Таким детям рекомендуется обязательно делать утреннюю гимнастику, аккуратно заниматься физкультурой в школе. В ряде случаев можно включать в утреннюю гигиеническую гимнастику специальные физические упражнения для устранения дефектов осанки.
Одной из важнейших предпосылок для правильного положения тела является правильно сконструированная мебель. Ученическая мебель должна соответствовать росту и пропорциям тела ребёнка, быть лёгкой и вместе с тем устойчивой, бесшумной, удобной, доступной для очистки.
Родителям необходимо объяснять детям важность правильной осанки, контролировать положение спины ребенка во время выполнения уроков и работы за компьютером, а при появлении признаков сколиоза сразу обращаться за помощью к детским специалистам. Раннее начало терапии – залог эффективного и быстрого выздоровления, сохранения здоровья позвоночника и всего опорно-двигательного аппарата ребенка.
Руководитель РГУ «Алтынсаринское
районное управление санитарно-
эпидемиологического контроля»
Альмаганбет А.Ж.